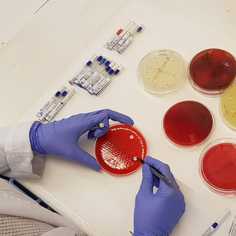
company photo

REPARTIDOR/A MOTO ALAQUAS (jornada parcial+ moto de empresa)
hace 15 horas
€8.4–€8.6 por hora
Jornada parcial
Alaquàs
Buscamos personal de reparto en moto en Camí Vell de Torrent, 17, 46970 Alaquàs, Valencia con disponibilidad de comidas y cenas, que tengan ganas de crecer con nosotros, que estén motivados y que quieran formar parte de nuestros ¡GRANDES EQUIPOS! Funciones: • Reparto de pedidos a domicilio, • Reposición de mercancía, • Limpieza de local, • Atención al cliente, • Requisitos:, • Residir cerca de la zona de trabajo., • Disponer de carnet de conducir coche o ciclomotor, • Disponibilidad para trabajar en comidas/cenas y fines de semana, • Ofrecemos:, • CONTRATO INDEFINIDO, • Incorporación inmediata, • MOTO DE EMPRESA, • 12-15 horas semanales más posibilidad de realizar horas complementarias, • Salario base + propinas + INCENTIVO POR CADA REPARTO, • Buen ambiente de trabajo, • Oportunidad de crecer profesionalmente con nosotros, • PIZZERÍAS CARLOS abrió su primer restaurante en 2009 y desde entonces no ha parada de crecer, actualmente cuenta con más de 80 restaurantes y un ambicioso proceso de expansión que nos llevará a todas las ciudades españolas., • Si quieres incorporarte a una empresa joven con mucha proyección en la que puedas desarrollarte profesionalmente apúntate a nuestra oferta,, • ¡¡¡QUEREMOS CONTAR CONTIGO!!!

Ricardo S.Activo hace 3 meses
Ricardo S.Activo hace 3 meses











